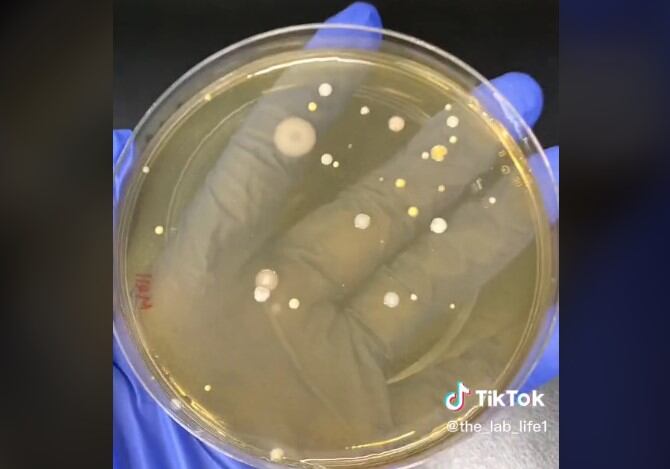

Con poco más de 28 millones de reproducciones, el video de una joven mostrando la gran cantidad de bacterias que hay en los secadores de manos de los baños públicos destaca como uno de los más virales en TikTok.
PUBLICIDAD
En su cuenta @the_lab_life1, la tiktoker, quien parece ser una microbióloga y bioanalista, hace pruebas con un secador de manos de un cine, otro de un centro comercial, otro de su trabajo y hace un secado de manos al aire libre.
Para recoger las muestras utilizó cuatro placas de Petri, una para cada secador y la que puso a secar al aire libre. Colocó cada placa debajo del secador de manos y luego las puso en la incubadora para que pudieran crecer las bacterias.
Recomendados:
Horóscopo de Los Ángeles para confiar y valorar el amor y la generosidad este jueves 16 de mayo
Horóscopo de hoy para abrir caminos de prosperidad este jueves 16 de mayo
“Espeluznante”: niñera queda espantada al escuchar extraña voz por monitor de bebé
“Advertencia de activación alrededor de 50 segundos”, fue su comentario en el video.
Al pasar el tiempo, las sacó y mostró los resultados. Las placas de los tres secadores tenían una gran cantidad de bacterias. El secador del cine tenía una luz azul para matar las bacterias, pero ni siquiera este se salvó del trágico y asqueroso resultado. Todos estaban contaminados, menos el que se secó al aire libre.
“Bueno, no me sorprendió del todo la cantidad de bacterias, sino más bien los diferentes tipos. Pensé que serían muchas bacterias normales relacionadas con la piel, pero me sorprendió encontrar muchos colores y géneros diferentes”, compartió la usuaria @the_lab_life1 con Fox News Digital.
@the_lab_life1 Trigger warning around 50 seconds 😬 #fyp #science #lab
♬ Dog Days Are Over - Florence + The Machine
Comentarios
La comunidad tiktoter se mostró impresionada por la gran cantidad de bacterias en los secadores de manos. Muchos lamentaron tener tantos años usándolos en los sitios públicos, sin saber que era un nido de bacterias.
“La neta jamás me había planteado qué podía no ser higiénico”, “siempre llevo una toalla conmigo o sacudo mis manos, las secadoras me parecen lo peor”, “por fin algo que hago bien, jamás uso los secadores”, “no me seco más”, “gracias por esto, finalmente se lo demostraré a mi pareja para que deje de usar secadores de aire.”, fueron algunos comentarios en la publicación de la tiktoker.
Alguien dijo que “vi a un científico decir que no es el secador de manos en sí, es solo que el secador de manos está expulsando el aire del baño”, a lo que la tiktoker respondió que “sí, eso es. Entonces, todos los aerosoles bacterianos del baño básicamente están siendo empujados hacia tus manos”.